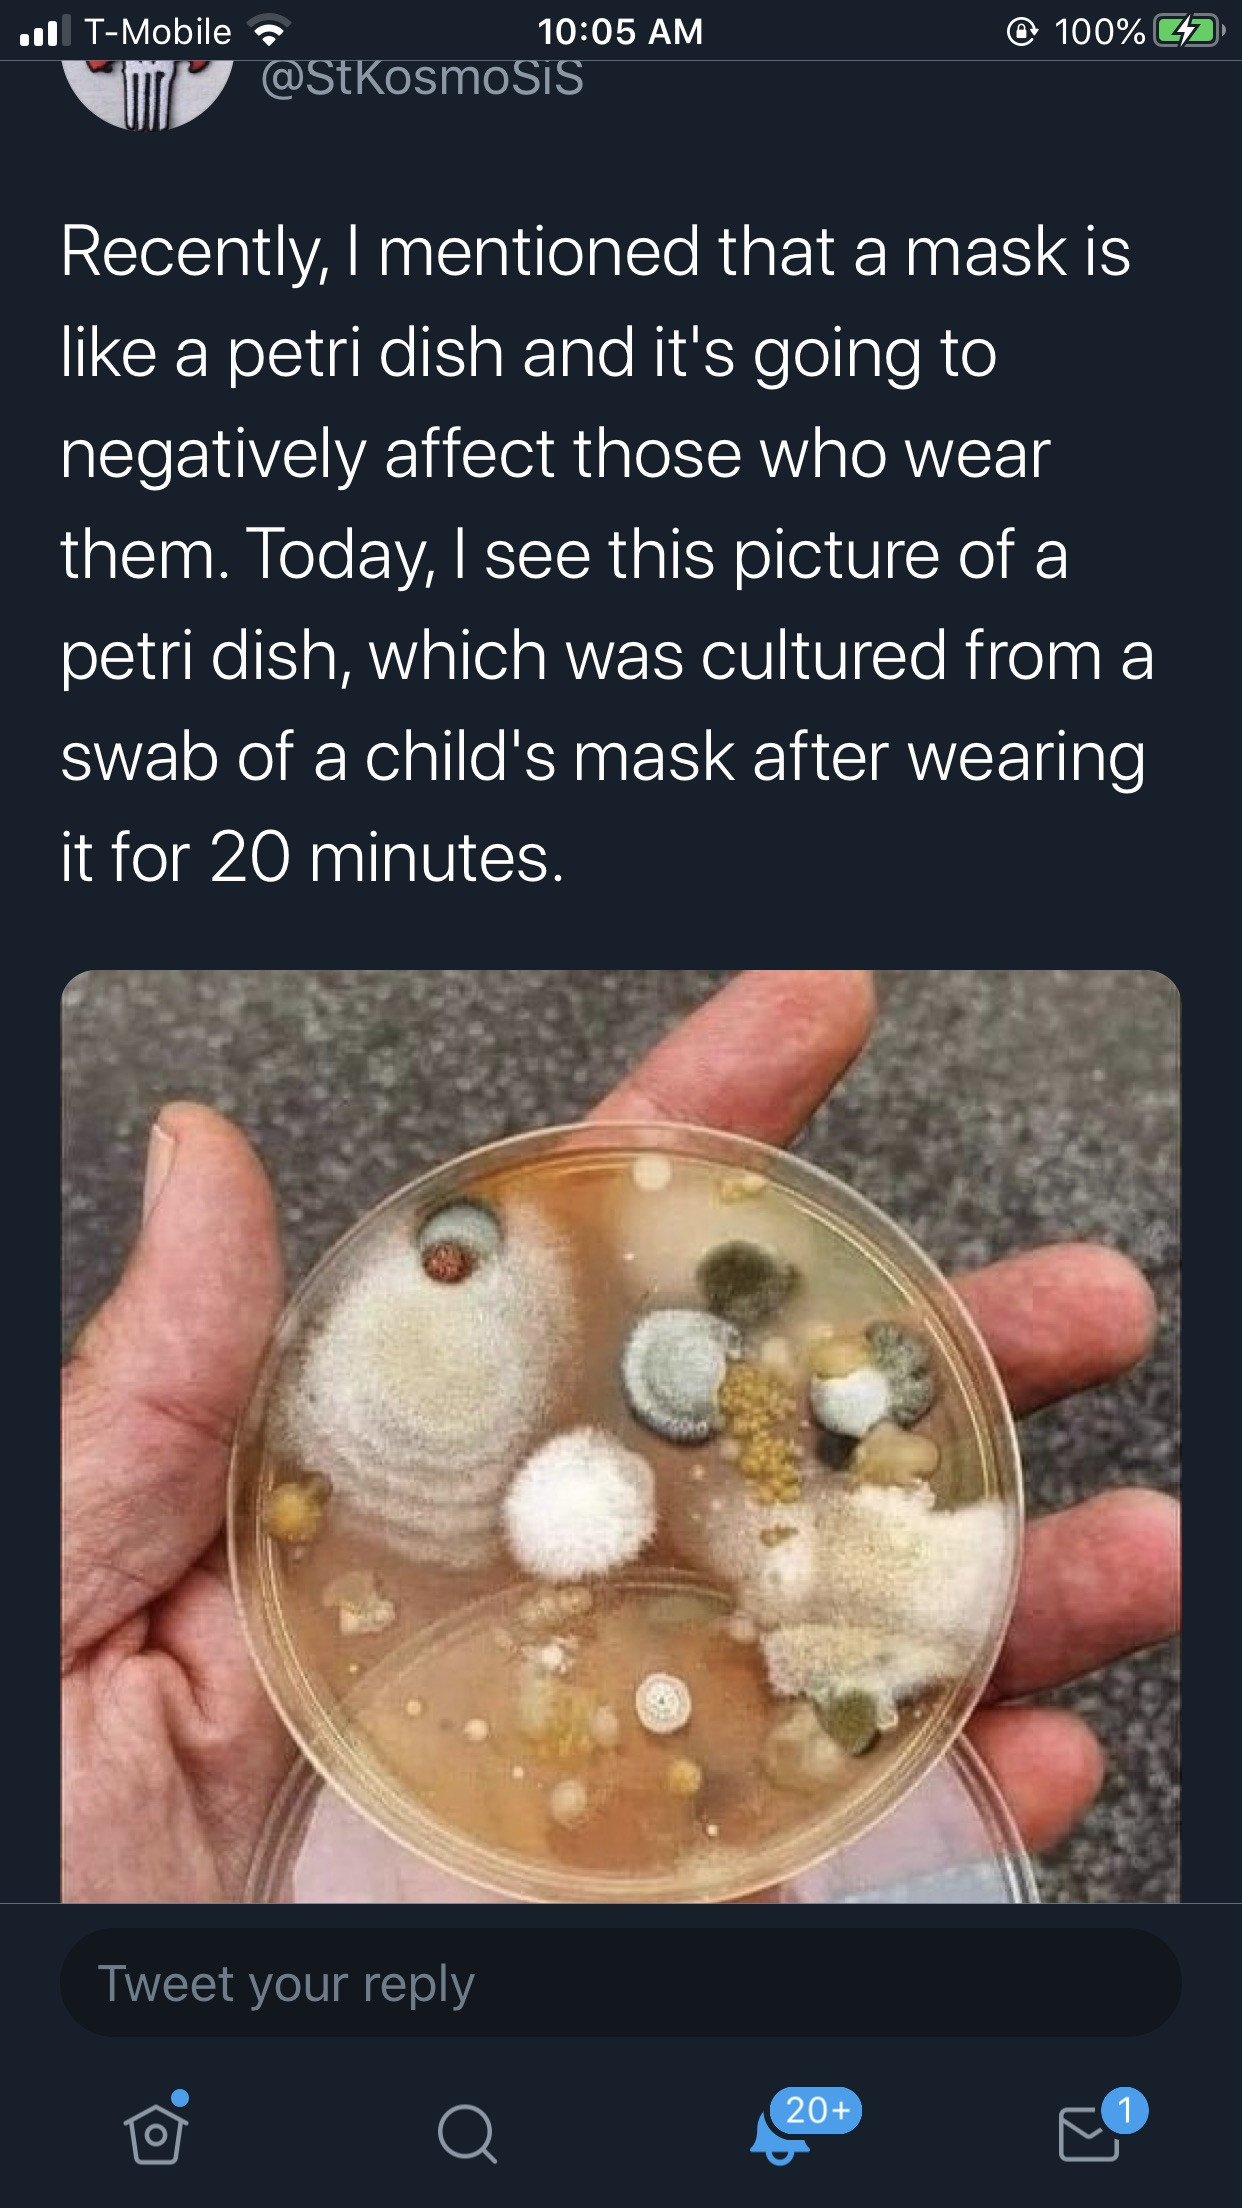

Angelzplay Design ⭐️⭐️⭐️
@Angelzplay
13 February, 02:57
Notice: Undefined index: tg1tga_access in /home/admin/www/anonup.com/themes/default/apps/timeline/post.phtml on line 396
Brad Smith
@drkHMRpally
13 February, 03:19
In response Angelzplay Design ⭐️⭐️⭐️ to her Publication
Please dont. Because this is 100% Fabricated bullshit. Sorry
Notice: Undefined index: tg1tga_access in /home/admin/www/anonup.com/themes/default/apps/timeline/post.phtml on line 396
so you dont think the face diapers are soaked in bacteria? i just pisted this because i just read a study valudating it. just reported. but you do you.
03:38 PM - Feb 13, 2021
In response Brad Smith to his Publication
Only people mentioned by Angelzplay in this post can reply